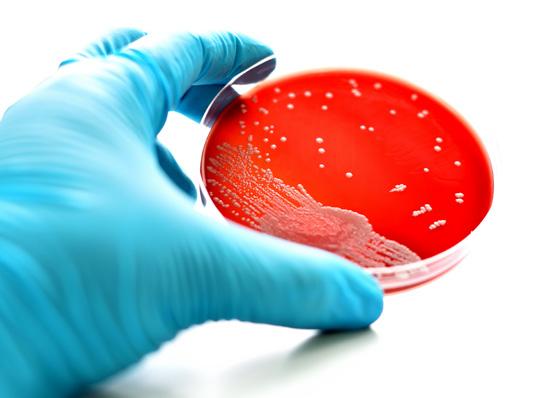

Tannhelsesekretæren
Medlemsblad for Tannhelsesekretærenes Forbund


Wenche Husby 14
![]()
Medlemsblad for Tannhelsesekretærenes Forbund


Wenche Husby 14


Manglende språkkunnskaper, Det er viktig at ansatte behersker norsk, slik at de kan kommunisere godt med kolleger og pasienter.
Fra tannhelsesekretær til lærer Som tannhelsesekretær har du muligheter til å studere videre for å bli faglærer.

Kurskalender for 2018
Parat tilbyr en rekke kurs gjennom hele 2018.


Inneholder både klorheksidin og fluor
Flux PRO Klorhexidin Skyll
0,12% Klorheksidin
0,2% NaF
0% Alkolhol

Smak av Coolmint
Flux PRO Klorhexidin inneholder både klorheksidin og fluor. Produktene er for kortidsbehandling eller etter anbefaling fra tannhelsepersonell. Som øvrige Flux produkter er de uten alkolhol og parabener. Utviklet i samarbeid med skandinavisk tannhelse.
Dosering:
Voksne og barn over 12 år: Brukes 1–2 ganger daglig i inntil to uker eller etter anbefaling fra tannhelsepersonell. Skyllen har en praktisk doseringspumpe som gir riktig dosering hver gang.
Flux PRO Klorhexidin Gel
0,12% Klorheksidin
1000 ppm F
0% Alkohol
Smak av Coolmint
Har du fluxet i dag?
2 Forbundsleder har ordet
6 Småstoff
10 Manglende språkkunnskaper
14 Trøndernes fylkesfusjon
18 Fra tannhelsesekretær til lærer
20 Vervesuksess på Nordental
22 Pasientbehandling og endobehandling i Troms
24 Omlegginger i kø på veifronten
28 Kurskalender for 2018
32 Dyrekjær skadedyrbekjemper
36 Parat informerer
38 Spørsmål fra medlemmer
40 Kryssord, sudoku, anagram og på kryss og tvers
42 Leder i Parat

Flere tannhelsesekretærer i Norge er flerspråklige. Noen tannlegesentre mottar klager fra pasienter, men tannlegesentrene understreker at de er svært positive til å ha et mangfoldig miljø på jobb.
Tannhelsesekretær og daglig leder på Oslo tannlegesenter, Labiba Abu Nima. Foto: Trygve Bergsland.

Utgis av: Tannhelsesekretærens
Forbund tilsluttet Parat
Tannhelsesekretærens Forbund, Lakkegata 23 Postboks 9029 Grønland 0133 OSLO
www.thsf.no www.parat.com
Besøksadresse: Lakkegata 23
Telefon: 21 01 36 00
Teleaks: 21 01 38 00
Epost: thsf@parat.com
Ansvarlig redaktør: Trygve Bergsland
Mobil: 905 85 639
Epost: trygve.bergsland@parat.com
Leder: Gerd Bang-Johansen Mobil: 984 88 100
Epost: gerd.bang.johansen@parat.com
Forsidefoto: Gorm K. Gaare. Avbildet: Wenche Husby.
Alle illustrasjonsbilder i bladet som ikke er kreditert er levert av iStock.
Redaksjonen avsluttet: 20.11.2017
Materiellfrist neste nr: 6.2.2017

Fra tannhelsesekretær til lærer
Som tannhelsesekretær har du muligheter for å studere videre. Lærer på ungdomsskolen og videregående kan være en mulighet.

Parat tilbyr en rekke kurs gjennom hele 2018. I tillegg til kursoversikt finner du også datoer for andre store arrangementer i kalenderen.
ISSN: 1504-5714
ISSN: 1890-9116 (online)
Layout: 07 Media, avd. Moss www.07.no
Telefon: 22 79 95 00
Trykk: Ålgård Offset AS www.ao.no
Telefon: 51 61 15 00

Høgskolen i Oslo og Akershus ved Kjeller. Foto: Dag Spant


Bezawit (9) bor i slummen i Etiopia. Hennes høyeste ønske er å gå på skole, men for at familien skal klare seg, er hun nødt til å arbeide store deler av dagen. Uten utdanning har Bezawit små sjanser til å komme seg ut av fattigdommen.
Bezawit (9) bor i slummen i Etiopia. Hennes høyeste ønske er å gå på skole, men for at familien skal klare seg, er hun nødt til å arbeide store deler av dagen. Uten utdanning har Bezawit små sjanser til å komme seg ut av fattigdommen.
Det er ikke lett å forstå hvordan hun har det. Men du har kanskje tenkt på hvordan hun burde hatt det? Tenkt at du vil hjelpe?
Det er ikke lett å forstå hvordan hun har det. Men du har kanskje tenkt på hvordan hun burde hatt det? Tenkt at du vil hjelpe?
Blir du Plan-fadder i dag, gir du barn som Bezawit en bedre framtid.
Blir du Plan-fadder i dag, gir du barn som Bezawit en bedre framtid.
Send SMS FADDER til 03123 www.plan-norge.no
Send SMS FADDER til 03123 www.plan-norge.no


Tannlegekontorene i Norge er, som helsevesenet ellers, en multikulturell arbeidsplass. Vi som arbeider på tannlegekontor, i tillegg til brukere og pårørende, er mennesker med ulik kulturell bakgrunn og språk. Det er derfor viktig at vi har et felles språk å kommunisere på når vi er på jobb.
Likestillings og diskrimineringsombudet sier også at «Et felles arbeidsspråk vil kunne være et arbeidsmiljøspørsmål for å sikre at alle ansatte vet hva som blir sagt og at det ikke dannes klikker»
Arbeidsplassen er en arena hvor fremmedspråklige, eller flerspråklige, får en unik mulighet til å praktisere og utvikle det norske språket. God integrering er helt avhengig av at man forstår og praktiserer språket i det landet man er bosatt i.

Arbeidsplassen er også en god arena for dialog og fellesskap. Et felles arbeidsspråk er helt avgjørende for et godt og trygt arbeidsmiljø.
De fleste innvandrere ønsker å bevare sitt morsmål og lære sine barn og barnebarn morsmålet. Det er udelt positivt å lære og praktisere morsmål hjemme, ikke bare for egen del, men også for tannhelsetjenestens mange fremmedspråklige pasienter. Flerspråklige kan benyttes som tolker og tannhelsetjenesten oppfyller dermed
Med vennlig hilsen
kravet i Pasient og brukerrettighetsloven.
Pasient og brukerrettighetsloven sier i kommentarene til paragraf 35: Barn eller andre familiemedlemmer skal som hovedregel ikke brukes som tolk. (…) Å tolke er et stort ansvar, som krever modenhet, bred kunnskap og spesifikke ferdigheter.
Mange har tatt til orde for at det er diskriminerende å bli pålagt å snakke norsk på jobben, men til dette har likestillings og diskrimineringsombudet uttalt følgende:
Det kan være saklig og nødvendig å forby andre morsmål enn norsk på arbeidsplassen dersom bruken av morsmål for eksempel skaper misforståelser og problemer.
Kolleger på en arbeidsplass bør benytte et felles språk for å dele erfaring og kunnskap. Samtidig har vi alle et ansvar for å skape gode samtaler kolleger imellom og bidra til positive relasjoner og fellesskap på arbeidsplassen.
Gerd Bang-Johansen
Tannhelsetjenesten i Sør-Trøndelag samlet
på Røros. Foto: Wenche Husby

I oktober var tannhelsetjenesten i SørTrøndelag samlet på Røros i to dager til felles etatsmøte. Temaet var «Trygge barn i tannbehandling» og «Profesjonsetikk i tannhelsetjenesten». Etatsmøtet ble supplert med et medlemsmøte for tannhelsesekretærene, der det ble informert om resultatene fra det lokale lønnsoppgjøret.
Hovedtillitsvalgt for ThsF, Wenche Husby, sier dette var en historisk samling, som den siste for SørTrøndelag, før sammenslåingen med NordTrøndelag. – Neste møte blir i Trøndelag fylkeskommune, som er det nye navnet fra 1. januar 2018.
Folkehelseinstituttets (FHI) folkehelserapport.
Et problem med tannregulering kan være at tennene ikke blir stående som planlagt etter reguleringen. Et protein kan hindre at tenner flytter seg i munnen.
Proteiner kan sammenlignes med små nøkler som låser opp ulike celler og gir beskjed om at de skal utføre en bestemt oppgave. Nå viser forskning ved Det odontologiske fakultet at et bestemt protein; adiponektin, kanskje kan påvirke hvordan en tann forflytter seg i munnen.
Kilde: Uniforum

En test av tannblekemidler gjennomført av NRK Forbrukerinspektørene, avslører ulovlige stoffer i midler til hjemmebleking som er kjøpt på nettet. NIOM (Nordisk institutt for odontologiske materialer), fant ulovlige mengder av blekestoffet hydrogenperoksid i to av de fem midlene som ble undersøkt, skriver nrk.no.
– Jeg fraråder bruk av disse blekemidlene. Dette er ikke trygt. Det kan gi etseskade i tannkjøttet, skade emaljen og på sikt nerven, sier NIOMs direktør, professor Jon E. Dahl til NRK.
I Norge og EU er det av helsemessige grunner ikke lov å selge tannblekemidler med mer enn 0,1 prosent hydrogenperoksid til andre enn tannleger.
Kilde: NRK

Tannleger som behandler pasienter utenfor den offentlige helsetjenesten har plikt til å melde seg inn i tilskuddsordningen i Norsk pasientskadeerstatning (NPE), og betale et årlig tilskudd. Tilskuddet skal dekke NPEs utredning av erstatningssaker og erstatningsutbetalinger.

Det er kun NPE som dekker pasientskader. Andre forsikringer vil ikke dekke de samme forholdene ifølge NPE.
Professor Fernanda Petersens forskergruppe ved Institutt for oral biologi (IOB) er tildelt åtte millioner kroner fra Forskningsrådet for å forske på antibiotikaresistens hos
premature
Hvert år dør tusenvis av for tidlig fødte barn av infeksjoner som ikke lenger kan behandles med antibiotika, på grunn av resistens. Petersen og hennes kollegers forskningsprosjekt søker å finne ut hvordan man bedre kan beskytte disse premature mot infeksjoner som er resistente mot antibiotika.
Kilde: Uniforum

Med den nye «TannSkrekk»appen kan tannlegebesøk bli enklere for mange nordmenn. Mange gruer seg til å gå til tannlegen. Så mange som 7 av 10 har enten mild, moderat eller alvorlig tannbehandlingsvegring.
Tannhelsetjenesten kompetansesenter MidtNorge (TkMN) lanserer appen, som er et selvhjelpsverktøy.
Kilde: TkMN)


Tannlege Rolf Johansen og tannhelsesekretær Heidi Johansen. Foto: Svalbardposten/ Christopher Engås.
Etter 40 år ved tannlegestolen, derav 17 på Svalbard, er det slutt for tannlege Rolf Johansen.
Han har en spesiell plass blant Longyearbyens befolkning, og det vakte nasjonal oppmerksomhet da tannlegen ble Longyearbyens mest populære tjenesteyter i 2015.
Tannlegens forsiktige og lune vesen har betrygget mange som har et snev av tannlegeskrekk.
Kilde: Svalbardposten


Tannhelsepersonell har plikt til å varsle barnevernet når det er grunn til å tro at et barn blir mishandlet eller opplever alvorlig omsorgssvikt.
Tannhelsepersonell skal i sitt arbeid være oppmerksom på forhold som kan føre til tiltak fra barnevernets side og har plikt til å varsle når det er grunn til å tro at et barn blir mishandlet i hjemmet eller det foreligger andre former for alvorlig omsorgssvikt. Dette følger av helsepersonelloven paragraf 33.
Kilde: Helsedirektoratet
WHO advarer: Det investeres altfor lite i forskning og utvikling av nye typer antibiotika, ifølge Verdens helseorganisasjon. Resultatet kan bli at vanlige operasjoner og kirurgiske inngrep blir dødelige, skriver Dagens Næringsliv.

Om du jobber dag eller natt kan påvirke tennene dine, viser en svensk studie.
Det er tidligere kjent at utdanningsnivå og økonomi påvirker folks tannhelse. Jo kortere utdanning og jo svakere økonomi, jo dårligere står det til med ten nene. Nå viser en studie fra Gøteborg at også nattarbeid har en negativ innvirkning på tannhelsen. Skiftarbeidere som jobber natt har dårligere tannhelse enn dagarbeidere.
Kilde: Halden Arbeiderblad


Gründerne bak Colosseumklinikken har kjøpt opp flere praksiser i Bodø, og vil nå samle alle i en stor og moderne kliinikk i det nye Ramsalt prosjektet – som blir betegnet som en helt ny bydel i Bodø. – Nå driver de klinikkene der de er, så flytter vi over til Ramsalt og lager en stor klinikk der. Det kommer til å bli en stor satsing, med alle spesialister, forteller gründer av Colosseumsklinikken, Gard Lauvsnes til Avisa Nordland.

Legemiddelverket tar nå i bruk den nye bivirkningsdatabasen VigiNor, som gjør det lettere å dele data med andre aktører og analysere dataene på en god måte.
VigiNor er tilpasset en ny, internasjonal meldingsstandard. Standarden sier hva en bivirkningsmelding skal inneholde og gjør det mulig å utveksle meldinger med andres databaser. Det er primært snakk om å utveksle meldinger med det europeiske legemiddelkontoret EMA, som igjen utveksler data med WHO.
Kilde: LMI
Flere femåringer får hull i tennene. Fylkestannlegen i Hedmark, Claes T. Næsheim, mener smågodt på salg bidrar til dette.
– I 2016 hadde 10 av 19 fylker en tilbakegang i andelen femåringer med null hull. Endringene er små, men i


Å pusse med kull skal gi deg hvitere tenner, lover produktet. Selv produsenten innrømmer at kull bare er tull. Nå advarer eksperter mot den nye trenden, som kan gi syreskader på tennene.
I Norge er det særlig to kullprodukter som markedsføres hyppig: NAO og COCO by Skintechnologies. Begge kulltannblekingsproduktene inneholder aktivt kull fra kokosnøttskall og lover å bleke, polere og fjerne misfarging på tennene dine.
– Kulltannblekingsprodukter kan ikke bleke. Skulle tennene oppleves hvitere etter at man har pusset tennene med dette, er det i så fall fordi det svarte pulveret fester seg i tannkjøttet, slik at man får en større kontrast i munnen, sier Jon E. Dahl, som er professor i odontologi ved Nordisk institutt for Odontologisk Materialprøving (NIOM).
Kilde: TV2
Hedmark gikk vi fra 84 prosent kariesfrie femåringer i 2014 til 83 prosent i 2016. Dette er ingen stor negativ endring, men på 1990tallet ble tannhelsen for femåringer stadig bedre til den rundt 1998 ble dramatisk dårlig, sier Næsheim.
(Gudbrandsdølen)
Munn og tenner bør behandles på lik linje med resten av kroppen når det gjelder egenandeler for helsetjenester, mener Pensjonistforbundet.
– Det er urimelig at utgiftene til tannbehandling ikke inngår i et egenandelstak. Frykt for store tannlegeutgifter gjør at enkelte ikke oppsøker tannlegen. Det kan medføre dårligere fysisk og psykisk helse og sosial isolasjon, sier Harald Olimb, generalsekretær i Pensjonistforbundet.
Elever som skal bli tannhelsesekretærer og helsesekretærer, sliter med å få praksisplass.
– Det har vært vanskelig i alle år, men det blir bare verre og verre å skaffe praksisplasser, sier Gerd Runhovde, faglærer på helseservicefag på Greåker videregående skole til Sarpsborg Arbeiderblad.
Helseservicefag er et utdanningsløp som fører til de autoriserte yrkene helsesekretær, tannhelsesekretær og apotektekniker. Elevene går tre år på videregående og skal ha praksis seks og ni timer i uken de to første årene.

I forslaget til statsbudsjett for 2018 foreslår regje ringen en bevilgning på 10 millioner kroner til et forprosjekt for et planlagt bygg for klinikkene til Det odontologiske fakultetet ved Universitet i Oslo.
Pengene går til Statsbygg som skal bruke midlene til å organisere en plan og designkonkurranse. Først avsettes det midler til et forprosjekt, deretter avsettes det en startbevilgning som innebærer et klarsignal for å starte selve byggeprosessen.
Kilde: Uniforum


Flere tannhelsesekretærer i Norge er flerspråklige. Noen tannlegesentre mottar klager fra pasienter, men tannlegesentrene understreker at de er svært positive til å ha et mangfoldig miljø på jobb. Språk er imidlertid en viktig del av jobben.
Av: Amalie Solnørdal Nærø

Daglig leder ved Oslo Tannlegesenter, Labiba Abu Nami. FOTO: Ragni Eliassen

Som pasient er det svært viktig at man føler seg forstått. Når en ringer til et tannlegesenter har man kanskje smerter eller er bekymret for helsen sin, og følelsen av å ikke bli forstått kan være vanskelig.
Lærer språket bedre for hver dag Daglig leder ved Oslo Tannlegesenter, Labiba Abu Nima, understreker først og fremst at det viktigste er at en tannhelsesekretær utfører jobben sin riktig og gjør arbeidsoppgavene som kreves. Likevel er språk en viktig del av jobben, og Abu Nima forklarer at det har kommet til nytte å ha flerkulturelle ansatte;
– Vi er så heldige at vi har mye mangfold blant våre ansatte. Det er veldig behjelpelig hvis vi får flerkulturelle pasienter, som kan få hjelp av våre ansatte dersom de kan snakke samme språk. Men selvfølgelig er det viktig at våre ansatte behersker norsk, slik at de kan kommunisere med pasientene på best mulig måte, sier Abu Nima.
Hun sier de har et fåtall av ansatte som ikke snakker flytende norsk, men at det fungerer fint på Oslo Tannlegesenter. Hun opplever at de ansatte er flinke til å dobbeltsjekke at de har skjønt hva som har blitt sagt.
– De fleste kommuniserer veldig bra. Det viktigste er å sjekke at pasienten har skjønt det som blir sagt ved at en dobbeltsjekker med pasienten. Dette er viktig for alle parter og ikke bare dem som ikke snakker flytende norsk. Det er også viktig at de ansatte forstår selv at de må spørre en kollega om hjelp dersom de trenger det, sier Abu Nima.
Hun tror nylig ansatte som ikke er helt flytende i norsk vil lære mye bedre dersom de faktisk får prøve seg i jobben raskt. Hun trekker frem et eksempel om en ansatt fra Polen som nesten ikke kunne
norsk da hun startet, men som nå er svært flink.
– Det er fordi hun fikk trent seg. I starten fikk hun andre oppgaver som ikke krevde direkte kontakt med pasienter, for eksempel sterilarbeid. Nå har hun utviklet seg så bra at hun kan kommunisere direkte med pasienter gjennom å betjene resepsjonen eller ta telefonen. Det å bygge seg opp gradvis tror jeg er viktig, sier Abu Nima.
Som daglig leder mener Abu Nima at det er viktig å se den ansatte og være en brobygger. Hun tror ikke det er lurt å plassere en ansatt som ikke er god i norsk rett i resepsjonen, men heller se hvor vedkommende bør plasseres for å kunne bygge opp språket best mulig.
– Det er viktig å gi slike muligheter. Selvfølgelig er kurs og alt sånt viktig på forhånd, men man blir aldri ferdig på skolen.
Kan ødelegge for andre søkere Janne Martinsen er assisterende daglig leder ved Galleri Osloklinikken. Hun sier at de ønsker et mangfold blant sine ansatte og alltid er villige til å gi motiverte søkere en sjanse.
– Vi har en ansatt som snakket mest engelsk da hun begynte, men som gjennom samhandling med pasienter og kolleger har blitt bedre hver dag. Arbeidsinnsatsen var og er helt upåklagelig, og det er det som er noe av det viktigste, sier Martinsen.
Når det gjelder tannhelsesekretærer vil arbeidsoppgavene variere etter hvor drevne de er i norsk. Galleri Osloklinikken har spesialister og allmenntannleger, så det blir dermed individuelt hvordan norskkunnskapene spiller en viktig rolle.
– Det er jo klart at noen arbeidsoppgaver blir vanskeligere å løse dersom språkferdighetene ikke er helt på plass, men da kan personen for eksempel jobbe med sterilisering og så videre, sier Martinsen.
Hun understreker at de ønsker primært ansatte som kan snakke, skrive og forstå norsk, men at det for dem ikke er et veldig stort krav dersom de har potensiale og kunnskap. Likevel kan de da ikke få alle oppgavene tannlegekontoret kanskje skulle ønske at de kunne utføre.
– Vi har møtt på noen utfordringer med flerspråklige ansatte. Det hender at vi får tilbakemeldinger fra pasienter dersom en ansatt er vanskelig å forstå. Dette gjelder kanskje spesielt eldre mennesker med dialekt, og da kan misforståelsene gå begge veier, sier Martinsen.
Generelt mener Martinsen at det går veldig fint å ha ansatte uten norsk som morsmål, men at det er viktig at de har en balanse på bemanningen.
– Det kan dessverre ødelegge for fremtidige søkere per i dag, fordi vi allerede har en ansatt med litt språklige utfordringer. Men vi er alltid åpne for å gi folk en sjanse, sier hun.
Kan bidra med mye
President i Tannlegeforeningen, Camilla Hansen Steinum, sier at det er finnes ulike typer språkkrav til helsepersonell.
– Det jeg tenker om tannhelsesekretærene er at deres rolle på tannklinikkene er rettet mot pasientene. De er gjerne de første pasienten møter i telefonen eller på klinikken, så jeg vil tro at de fleste pasienter mener det er viktig at man kan kommunisere godt med den de møter, sier Steinum.
På en annen side tror hun flerkulturelle tannhelsesekretærer kan bidra med mye, spesielt siden pasienter i Norge har flere ulike nasjonaliteter.
– Noen steder kan flerspråklige sekretærer være en fordel når man får pasienter med et annet språk enn norsk, kanskje særlig i de store byene. Men det er generelt viktig i helsevesenet at pasienter møter ansatte som skjønner hva du har å si og kan kommunisere godt med, sier Steinum.
Når en tar kontakt med helsevesenet har man ofte et problem, mange gruer seg til å ta den telefonen, så Steinum tror noen pasienter kan føle at det er vanskelig dersom de møter en som det er vanskelig å kommunisere med.
Opplevde vansker på telefonen
Marita Haaker (24) studerer pedagogikk i Bergen. Hun har hatt enkelte opplevelser som tannlegepasient der kommunikasjonen var krevende.
– Jeg skulle til tannlegen for en vanlig sjekk, men hadde fra før av en del smerter i en av visdomstennene. På telefonen pratet jeg med en i resepsjonen som jeg følte ikke helt forsto hva jeg mente, men det gikk fint da jeg kom til kontoret og fikk forklart det ordentlig, sier Haaker.
Hun opplevde sekretæren på kontoret som veldig imøtekommende og flink til å lytte, og synes ikke at språket var noe problem. Helsesekretæren formidlet alt riktig og timen gikk fint. Men hun kan forstå at noen pasienter kan føle at det er krevende dersom den ansatte har problemer med språket.
– For min del var det kun litt vanskelig på telefonen, men jeg følte ikke at det var så problematisk at jeg ble bekymret for timen eller noe slikt. Jeg kan derimot forstå det hvis andre pasienter føler det kan være vanskelig, sier Haaker.
Hun trekker frem eldre mennesker med dårlig hørsel som pasienter som kanskje vil synes det er utfordrende å møte en ansatt som ikke behersker språket godt nok. Men mener at det er viktig at alle i hvert fall får prøve seg i en jobb de har lyst på og som de er dyktige i.
– Det er viktig å gi alle en sjanse, og man lærer jo mye når man jobber tett på kolleger og pasienter som snakker språket man lærer seg. Så lenge de er dyktige i faget tror jeg de aller fleste tannhelsesekretærer klarer å håndtere jobben sin på en god måte så lenge de får hjelp med språket dersom de føler det trengs, sier Haaker.
De 140 tannhelsesekretærene i nye Trøndelag fylkeskommune er fredet med oppsigelsesvern i fem år. Hovedutfordringen for fylkessammenslåingen er både ulike lønnsvilkår og betydelige økonomiske forskjeller mellom de nordlige og sørlige tannhelsetjenestene.
Bare to uker etter at Wenche Husby ble hovedtillitsvalgt for tannhelsesekretærene i SørTrøndelag fylke, var det kickoff for sammenslåingen av Nord og Sør Trøndelag. Dermed ble det også ekstra oppmerksomhet på de til sammen 140 tannhelsesekretærene i det nye storfylket.
Bratt innkjøring
Den erfarne tannhelsesekretæren med fartstid som klinikkleder fikk en bratt innkjøringskurve som hovedtillitsvalgt, da hun straks måtte trå til for å bidra til organiseringen av det nye fylkets tannhelsetjeneste.
Dessuten fikk hun ansvaret for å tale også tannpleiernes sak i arbeidsgruppen, da den ble etablert som resultat av fusjonen. Det hele startet på den inneklemte mandagen16. mai 2016.
Som hilsen fra regjeringen i Oslo, fikk det splitter nye fylket rundt 20 millioner kroner mindre enn forventet i statsbudsjettet for 2018. Det spørs om det får utslag for
Av Magne Otterdal
fylkets tannhelsebudsjett, som ligger på samlet rundt 200 millioner kroner per år.
Men Trøndelag kan i alle fall spare ekstra utgifter til fyrverkeri, i og med at starten for storfylket sammenfaller med inngangen til nye året. Tirsdag 2. januar møter de ansatte i tannhelsetjenesten på jobb med Trøndelag fylke som arbeidsgiver.
Gitt at de 452 000 innbyggerne stort sett har tennene i behold, er det rundt 14 millioner trøndertenner å holde styr på for tannhelsesekretærer, tannpleiere og tannleger i Trøndelag fylke. På landsbasis representerer den fylkeskommunale tannhelsetjenesten rundt 3 400 årsverk og 3,2 milliarder kroner.
Fem års fredningstid
Et spørsmål som melder seg i bølgen av sammenslåinger i kommunal og fylkeskommunal sektor er nedleggelser av klinikker. De siste årene har rasjonalisering ført til nedleggelse av flere tannklinikker
landet rundt.
Det har ikke vært tema når strategien for det nye trønderfylkets tannhelsetjeneste er blitt meislet ut, ifølge tannhelsesekretærenes representant i arbeidsgruppen.
– Det har ikke vært noe tema å legge ned klinikker, sier Husby.
Hun mener tannhelsen kanskje er den av fylkesoppgavene som er minst berørt av sammenslåing. Og de ansatte i det nye trønderfylkets tannhelsetjeneste er blitt fredet en god stund.
– Vi har fått et oppsigelsesvern på fem år, konstaterer Wenche Husby.
Hun opplever pågang fra andre kolleger ellers i landet som ønsker å høre om erfaringene med sammenslåingen av trønderfylkene. Husby holder blant annet innledning om temaet på høstens Tannhelsekonferanse i Oslo i slutten av november.
Fylkestannhelsetjenesten vil reflektere utviklingen i befolkningen av Trøndelag fylke. Foto: Trøndelag fylkeskommune


Fylkestannlege Kari Strand ledet arbeidsgruppen for samordning av den nordlige og sørlige fylkestannhelsetjenesten i nye Trøndelag fylke. Foto: Inga Rossing/NTFK.
Harmonisering
Arbeidsgruppen for fylkestannhelsetjenesten i det nye Trøndelag Fylke avdekket en rekke forskjeller mellom sør og nord. En rekke særavtaler kom på bordet. Det viste seg å ikke være så lett å få grunnlagsmateriale for lønns og ansettelsesforhold.
– Hva var den største utfordringen?
– Det var særavtalene, både i nord og sør. Vi etterspurte lønnsoversikter, men det sitter langt inne å få ut lister. Det er ulike funksjonstillegg og andre lokale tillegg, som bonusavtaler. Det var vanskelig å få den fulle oversikten, sier Husby.
Det er nå lagt opp til en overgangsperiode på tre år for å oppnå lønnsharmonisering mellom nord og sør i det nye Trøndelag fylke. En bonusavtale som gjelder alle ansatte i sør er sagt opp fra 1. Januar 2018. Som erstatning får de ansatte i sør en kompensasjon fra 1. januar.
Tannhelsesekretærene i nord har benyttet denne bonusavtalen som argument for økt lønn under sine lokale forhandlinger i høst. Forhandlingene har ført frem og de får tillegg som er med på å starte
Tannhelsetjenester
Næringsutvikling
Opplæring
Regional utvikling
Kultur
Svært viktig Ganske viktig Verken viktig eller uviktig Ganske uviktig Svært uviktig Vet ikke/ikke aktuelt
En spørreundersøkelse blant innbyggerne i det nye trønderfylket viser at befolkningen mener tannhelsetjenester er svært viktig, og like viktig som næringsutvikling, blant fylkeskommunens tjenesteområder. Kilde: Trøndelag fylkeskommune
utjevning av lønn for sekretærene. Etter overgangen til ny fylkesorganisasjon i 2018, vil en begynne å få riktige tall som sammenligningsgrunnlag.
En god del tid gikk med til å diskutere insentivavtalene. Blant motargumentene er at bonuser og provisjon fordeles ujevnt og oppleves urettferdig, er ressurskrevende å administrere og konfliktskapende, og at arbeidsoppgaver som ikke utløser bonus nedprioriteres. Dette ifølge «Sluttrapport hovedprosjekt helse» som Tannhelsesekretæren har fått tilgang til.
Betydelige økonomiske forskjeller
Arbeidsgruppen ble ledet av fylkestannlege Kari Strand. I sluttrapporten beskriver Strand sammenslåingen som «i store trekk uproblematisk».
– De største utfordringene er knyttet til ulikheter i lønns og arbeidsvilkår, ulikt kostnadsnivå og ulike økonomistyringsmodeller, skriver fylkestannlegen i rapporten. Egne arbeidsgrupper jobber videre med disse spørsmålene.
I rapporten fremgår det at det er stor forskjell på utgiftsnivået for tannhelsetjenesten i nord og sør. Netto driftsutgif
ter har i nord ligget betydelig høyere enn landsgjennomsnittet, mens tilsvarende driftsutgifter i sør er betydelig lavere.
Det viser seg at tannhelsetjenesten i de to fylkene har vært drevet med ulike økonomistyringsmodeller. I nord er budsjett og økonomistyring sentralisert, mens det i sør har vært praktisert en mer desentralisert ordning hvor ansvar og budsjettkontroll er delegert til lokalt nivå.
Den sørtrønderske økonomimodellen er testet ut på tre klinikker i nord i 2017. De store ulikhetene i utgiftsnivå mellom nord og sør har vært en utfordring i arbeid med det første felles budsjettet for fylkestannhelsetjenesten i det nye trønderfylket. Om lønns og arbeidsvilkår heter det i sluttrapporten:
Tannhelsetjenesten i Trøndelag skal ha lønns og arbeidsvilkår som gjør den til en attraktiv arbeidsplass både for dagens ansatte og for dem vi har behov for å rekruttere i årene framover. Vilkårene skal tilpasses arbeidsmarkedet og organisasjonens økonomi. Den største utfordringen i arbeidet med harmonisering på dette området er ulike intensjonslønnsavtaler.

Bare to uker etter at hun ble hovedtillitsvalgt for tannhelsesekretærene i Sør-Trøndelag, gikk Wenche Husby i gang med forberedelsene til det nye storfylket. Hun deler erfaringer med kolleger i andre deler av landet hvor fylkessammenslåinger står på agendaen. Foto: Gorm K. Gaare.
Ledertillegg
Wenche Husby har selv erfaring som klinikkleder. Hun jobber ved Skaun tannklinikk. Det ble et tema i forhandlingene om det skulle etableres et funksjonstillegg i avtaleverket også for de tannhelsesekretærer som får klinikklederfunksjon.
Dette førte til diskusjoner om hvem på tannlegekontoret som er egnet for lederoppgaven. Husby opplevde en steil holdning fra arbeidsgiversiden, og det endte med nei til et generelt lederfunksjonstillegg for tannhelsesekretærer.
– Arbeidsgiver stod på sitt om at tannhelsesekretærer ikke skal få det sammen funksjonstillegget som tannpleier og tannlege. For tannhelsesekretærer som blir klinikkledere må tillegget forhandles individuelt, sier Husby.
Hun har selv hatt jobb som klinikkleder i to perioder i sin karriere som tannhelsesekretær i SørTrøndelag fylke. Hennes egen erfaring tilsier at tannhelsesekretærer faktisk er de som har potensiale som klinikkledere. – Tannhelsesekretæren er den som har den fulle oversikten på klinikken, mens tannlege og tannpleier er de som skal tjene inn pengene, sier Husby.
Hun mener derfor tannhelsesekretærene burde hatt det samme funksjonstillegget for klinikkleder som de to andre faggruppene i tannhelsetjenesten. Hun opplevde det som en utfordring innledningsvis i prosjektgruppen å ha oppgaven med å tale også tannpleiernes sak, særlig på dette området med funksjonstillegg for klinikkledelse. Det løste seg etter hvert, da en representant for tannpleiere ble koblet inn.
I spørsmålet om klinikkleder, refereres det i sluttrapporten til at SørTrøndelag har «et administrativt vedtak på at klinikkleder skal være tannlege». Videre at arbeidsgruppen «mener at ledere på distrikts og klinikknivå fortrinnsvis skal være tannleger».
– Flott klinikk med flinke folk Fylkesordfører i det nye trønderfylket, Tore O. Sandvik (Ap) har for sin del stolt publisert på Facebook sin tale fra åpning av ny tannklinikk på Ranheim i Trondheim. Klinikken til 3,5 millioner kroner ble innviet i førjulsstria 2016, for ifølge Sandvik å møte den forventede befolkningsveksten.
– Befolkningsveksten er nå så høy øst for Trondheim at eksis
terende klinikker ikke klarer å ta unna veksten. Og dette vil øke framover, ifølge fylkesordfører Sandviks Facebookinnlegg.
Bakteppet for trøndernes tannpleietilbud er endringer i klinikkstrukturen siden årtusenskiftet, med flere klinikksammenslåinger. Ifølge fylkesordfører Tore O. Sandvik er flere titalls tannklinikker renovert eller bygget nytt siden slutten av 1990årene.
– Hele 21 av 26 klinikker er bygget opp eller utbedret. Ranheim er den 22. i rekken av nye klinikker. Ranheim er så langt den eneste som ikke erstatter en eller flere klinikker, ifølge Trøndelags fylkesordfører.
Han kommenterer muntert åpningen på Facebook:
– Flott klinikk med flinke folk. Usikker på om de bruker helium…
Den nyfusjonerte Trøndelag fylkeskommune er Norges nest største fylke i areal med 41 000 kvadratkilometer. Administrasjonssenter og fylkesrådmann lokaliseres til Steinkjer, mens den politiske ledelsen med fylkesordfører lokaliseres i Trondheim.
Høgskolen i Oslo og Akershus utdanner tannhelsesekretærlærere på Kjeller utenfor Oslo. Foto: HIOA, Benjamin A. Ward

Som tannhelsesekretær har du muligheter for å studere videre. Lærer på ungdomsskolen og videregående kan være en mulighet.
Av: Amalie Solnørdal Nærø
En av mulighetene en tannhelsesekretær har for å utdanne seg til lærer er ved Høgskolen i Oslo og Akershus. Kjersti Johnsen er høgskolelektor ved skolen. Hun underviser for bacheloren Yrkesfaglærerutdanning i helse og oppvekstfag.
Får dybde i flere yrker Er du utdannet tannhelsesekretær, er over 25 år og har hatt praksis i to år kan du ifølge Johnsen søke opptak. – Enten med realfagskompetanse eller studiespesialisering. Denne utdanningen er annerledes enn PPUutdanningen (Praktiskpedagogisk utdanning) ved den er skreddersydd for å kunne undervise i helse og oppvekstfag i videregående skole. I tillegg til pedagogikk tilegner studentene seg med breddekompetanse, som handler om å få kjennskap til de ulike yrkene innenfor programområdet, sier Johnsen.
Ved å velge denne utdanningen vil du derfor lære om andre yrker innenfor helseog oppvekstfag. De som kan ta denne bachelorutdanningen, i tillegg til tannhelsesekretærer er blant annet hudpleiere, apotekteknikere, fotterapeuter, helsefagarbeidere, helsesekretærer, ambulansearbeidere og barne og ungdomsarbeidere. – I tillegg skal studentene fordype seg innenfor sitt eget fagområde. Tannhelsesekretærer kan velge å fordype seg i nyere forskning, som for eksempel dyrking av benceller for å reparere skader i kjeven. I tillegg kan studentene også fordype seg i temaer de ikke har lært seg tidligere, eller trenger fordypning i, sier Johnsen.
Etter endt bachelor kan du undervise på videregående nivå og på ungdomsskolen, i valgfag som arbeidslivsfag og i mat og helsefaget.
– Noen ungdomsskoler har også valgfag som heter «fysisk aktivitet og helse», og her vil studentene få skreddersydd undervisningskompetanse, sier Johnsen.
I tillegg til å kunne undervise i ditt eget fag får du kompetanse til å undervise på VG1 og VG2nivå. Yrkesfaglærere vil etter denne utdanningen også kunne undervise på fagskolenivå, men Johnsen kjenner ikke til noen tannhelsesekretærer som gjør det. – Utdanningen kan tas både på heltid og deltid. Heltid over tre år, men du kan også ta utdanningen på deltid over fire år. Studentene vil ha mye praksis i løpet av utdanningen og de må belage seg på en del selvstudier, i tillegg til at det er det er fem
ukesamlinger per semester på Høgskolen, sier Johnsen.
Trine (45) studerer for å bli lærer Trine Holme (45) gikk ut som tannhelsesekretær fra Bleiker skole i 1991. Siden har hun jobbet flere år både i det private og i det offentlige, men hadde en pause en stund etter hun flyttet ut av Oslo.
– Det var ganske vanskelig å få seg en fornuftig jobb igjen. Det ble mest timesbaserte oppdrag og noen vikariater i det offentlige. Siden jeg ikke fikk fast stilling noe sted, begynte jeg tilfeldigvis å jobbe litt på barneskoler og ungdomsskoler, sier Holme.
Hun fikk tilbud om ett års vikariat i offentlig tannlegetjeneste, men etter to år kjente hun at noe ikke stemte med kroppen hennes. Etter undersøkelser viste det seg at hun mest sannsynlig var allergisk mot bonding.
– Jeg fikk beskjed om å unngå limet og ble anbefalt å skaffe en annen jobb. Det var et sjokk, jeg kunne jo ingenting annet, sier Holme.
Etter litt om og men ble hun sendt til en karriereveileder som spurte om hun hadde vurdert å bli yrkeslærer. Det var en av de få utdannelsene Trine kunne ta uten studiespesialisering, og hun går nå på Høyskolen, der hun tar utdanningen på deltid og er nå i femte semester.
– Det er et veldig ålreit opplegg. Fordi vi har ukesamlinger kan man jobbe mye på siden. Det gjør de fleste av oss, sier Holme, som er den eneste av rundt 40 studenter som har tannhelsesekretærbakgrunn.
Det er med andre ord fokus på lærerutdanningen. Holme sier undervisningen er veldig praksisbasert med flere praksisperioder, både i skole og i yrkesfagene. De har blant annet praksis i andres yrker, og hun jobbet for eksempel en uke i hudpleie.
– Man blir godt kjent med alle helse og oppvekstyrkene, så vi lærer masse av hverandre. Siden vi har bakgrunn i yrket vårt, går det meste av undervisningen ut på det å kunne lære bort, sier Holme.
Målet er å få en stilling som lærer på VG1 i et av helsefagene. Drømmejobben er en

Trine Holme (45) måtte slutte i jobben som tannhelsesekretær og utdanner seg i dag til å bli lærer. Foto: Privat
av de få skolene i Oslo som har en egen tannhelsesekretærlinje, men det vil mest sannsynlig vise seg å bli ganske vanskelig. – Det er alt for få elever som søker seg til tannhelsesekretærlinjer, så det er lite å velge mellom. Da blir det selvfølgelig også færre læreplasser, sier Holme.
Trine understreker derfor at dersom du vurderer å videreutdanne deg til lærer må du være obs på at du må være interessert i selve læreryrket, fordi det kan hende at du ikke får undervise i akkurat tannhelsesekretæryrket med en gang.
Kun én skole med tannhelsesekretærlinje i Oslo
Hersleb videregående skole er i dag den eneste skolen i Oslo som tilbyr en egen utdanning til elever som ønsker å bli tannhelsesekretærer. Skolen har et eget laboratorium og en tannklinikk med tannlegestol og alt av utstyr.
– Vi utdanner femten til seksten elever i året. I tillegg har vi en klasse for voksenopplæring, sier rektor ved skolen, Anja Teig.
Skolen har en avtale om praksisplasser med Helseetaten i Oslo, avdeling tannhelsetjenesten.
– Elevene trenger relevant praksis mens de er under utdanning, sier Teig.
Elevene får prøve seg i jobb på tannlegekontorer med veiledere og lærere som følger opp. Det krever mye utstyr å gi disse elevene relevant og oppdatert opplæring. – Det er jo kostbart å utstyre en tannklinikk, så dermed blir ikke dette en utdanning som legges til mange skoler dersom det er få søkere, sier Teig.
Hele 33 nye medlemmer meldte seg inn i ThsF under årets Nordental-messe på Lillestrøm. Leder i ThsF, Gerd Bang-Johansen, sier Nordental er en viktig arena, både når det gjelder rekruttering og medlemspleie.
Av: Vetle Daler
ThsFlederen er strålende fornøyd med forbundets deltakelse på årets messe.
– På standen vår har det vært masse folk hele tiden, både eksisterende medlemmer, nye medlemmer og andre. Det er slitsomt

å stå her fra morgen til kveld, men det er verdt det, sier BangJohansen.
I løpet av messedagene har ThsF delt ut 250 «goodie bags» til medlemmer som har
besøkt standen.
– Dette er god medlemspleie og jeg er svært fornøyd med alle nyinnmeldingene i løpet av tre dager på Norges varemesse i Lillestrøm, sier BangJohansen.
På Nordental lanserte Cathrine Almeland ideen om å dra i gang en egen ThsF-klubb på Voss, der hun jobber og bor.
– Jeg og en kollega deltok på et Parat UNG-arrangement, og kom hjem igjen med mange gode ideer. Det er mange tannklinikker på Voss, men få er organisert. Jeg vet at mange henger seg opp i hva det koster, men vi er opptatt av hva vi får igjen. Det er trygt å ha forbundet i ryggen, jeg har selv hatt behov for juridisk bistand og fikk raskt svar da jeg kontaktet Parat, sier Almeland, som organiserte seg allerede som student.
Lisbeth Sognefest er ett av mange ThsF-medlemmer som tok turen innom standen på Nordental. Hun er tannhelsesekretær i Forsvaret og jobber i gardeleiren på Huseby i Oslo.


Tannhelsesekretær Heidi
Skaarer var strålende fornøyd med kurstilbudet på Nordental


Cathrine Narvesen
Nergaard fra Kongsvinger
tannklinikk er ny hovedtillitsvalgt i Hedmark


Elisabeth Johansen fra Torget tannlegesenter i Drammen var blant dem som meldte seg inn i ThsF på Nordental. Hun var ferdig utdannet tannhelsesekretær i 2008 og har fulgt med på ThsF siden hun gikk på skolen. – Jeg har ikke meldt meg inn før i dag, noe som var på tide. Det er veldig ålreit å ha Parat i ryggen, og bra at man kan få hjelp hvis man har spørsmål i tilknytning til jobben. Det er viktig å ha noen på vår side, sier Johansen
Den heldige vinneren av en iPad er Wenche Bjørkvall fra Langhus. Hun ble trukket ut blant besøkende på ThsFs stand på Nordental. Bjørkvall jobber på Oppegård tannklinikk i Akershus fylkeskommune og er en av de 178 ThsF-medlemmene som la igjen navnet sitt på ThsF-standen under årets Nordental-arrangement.

Førsteamanuensis i samfunnsodontologi, Linda Stein, og spesialtannlege i klinisk odontologi, Lars-Martin Berg, avholdt tidligere i høst et kurs i pasientbehandling og endodonti. Alt i regi av Tannhelsesekretærenes Forbund (ThsF), Parat, Fagforbundet og fylkestannhelsesjefen.
Av: Emma Kristvik Pettersen, hovedtillitsvalgt i Troms fylkeskommune for ThsF.
106 tannhelsesekretærer var samlet i Tromsø når tannpleier og førsteamanuensis i samfunnsodontologi, Linda Stein, foreleste om health literacy.

Pasientinformasjon og medvirkning
Health Literacy omhandler folks kunnskap, motivasjon og kompetanse til å få tak i, tolke, forstå og bruke helseinformasjon. – Vi lærte hva som kjennetegner personer med
mangelfull health literacy og hvordan man kan ta hensyn til pasienter og pårørende med mangelfull health literacy. Det å ikke forstå helseinformasjon kan føre til at pasientene ikke kan bruke de helserådene vi gir dem, eller ikke forstår de behandlingsalternativene tannlegen legger fram, sier Stein.
Pasientene har en lovfestet rett til å få informasjon, ifølge Pasient og brukerrettighetsloven, kapittel 3. Her er det beskrevet pasientens rett til å medvirke ved valg mellom tilgjengelige og forsvarlige undersøkelses og behandlingsmetoder. Medvirkningens form skal videre tilpasses den enkeltes evne til å gi og motta informasjon.
Stein fremhever at tannhelsesekretærene har muligheter til å fange opp og hjelpe disse pasientene, da tannhelsesekretæren ofte er den som tar inn pasienten og snakker med disse før tannlegen kommer inn.
– Tannhelsesekretæren har også en enklere måte å snakke på, som kan gjøre det lettere for pasientene å forstå informasjonen. Dette gjør det også enklere for pasientene å stille spørsmål, fremfor å spørre tannlegen som ofte oppfattes som autoritær, sier hun.
Samarbeid tannlege og tannhelsesekretær
Spesialtannlege i Klinisk odontologi, LarsMartin Berg, fore
Emma Kristvik Pettersen. Foto: Trygve Bergsland

Førsteamanuensis i samfunnsodontologi, Linda Stein, og spesialtannlege i klinisk odontologi, Lars-Martin Berg. Foto: Emma Pettersen
leste om endodonti og spurte retorisk om dette var noe for tannhelsesekretæren.
Berg gikk grundig igjennom alt fra diagnostisering til ferdigbehandlet tann, der deltagerne på kurset fikk en gjennomgang av de ulike filene og mekanisk rensing. Berg la også frem flere eksempler der det er fint å bruke firhendig samarbeid mellom tannlege og tannhelsesekretær.
– Et godt samarbeid mellom tannhelsesekretær og tannlege fører til effektiv og god endobehandling, sier Berg.
Innesalg
Plandent ansetter nå flere dyktige salgsmedarbeidere på innesalg. Salgsarbeidet fokuserer på salg av forbruksutstyr, kundeavtaler og kampanjer over telefon. Stillingen krever kommersiell innstilling, struktur, gode kommunikasjonsevner og faglig kunnskap.
Les mer og søk stillingen på www.orion.no
Plandent er totalleverandør av tannlegeutstyr og forbruksvarer til den offentlige og private tannhelsetjenesten, og er et landsdekkende fullservicedepot med høy servicegrad og høy kvalitet på varer og tjenester. Selskapet er størst i det norske markedet og er økonomisk solid. Plandent har ca. 90 ansatte og holder til i moderne lokaler på Brynseng i Oslo. www.plandent.no

SYNES DU DETTE VIRKER SPENNENDE OG VIL HØRE MER?
Ta kontakt med Geir Olderbakk, tlf. 900 28 283 eller Celin Voldsæter, tlf. 926 26 253 hos rekrutteringsselskapet Orion Search


Strekningen E18 Langangen – Grimstad er et av utbyggingsområdene i Nye Veier, men der strekningen er delt opp i seks selvstendige prosjekter.
Illustrasjon: Nye Veier.
Uansett hva du mener om planlegging og drift av norske veier kommer du ikke unna følgende: Vi står midt oppe i store endringer, som påvirker bilister, politikere og ikke minst ansatte og deres tillitsvalgte.
Av: Tellef Øgrim
Overføring av oppgaver til fylkene fra Statens vegvesen og omlegging av trafikkstasjonene utgjør til sammen forandringer som forandrer mange ansattes hverdag.
Nye Veier
Ambisjonene som ligger bak er like mange som diskusjonene som pågår, i offentlighet eller i lukkede rom. Blir det virkelig billigere, sikrere, raskere, mer effektivt og bedre kvalitet?
Oppstarten av Nye Veier AS er den omleggingen som har kommet lengst. Fjerde mai 2015 ble det statlige eide aksjeselskapet stiftet.
1. januar 2016 overtok Nye Veier ansvaret for utbygging og drift av flere motorveier fra Statens vegvesen.
Selskapets oppgaver omfatter å planlegge, bygge, drifte og vedlikeholde viktige
hovedveier. Nye Veier skal, i følge selskapet selv, være en slank og effektiv byggherreorganisasjon, med et mål om å sikre helhetlig og kostnadseffektiv utbygging og drift av trafikksikre hovedveier.
En skeptisk fagbevegelse
I første omgang har Nye Veier ansvar for å bygge ut Europavei 39 mellom Kristiansand og Ålgård, Europavei 18 og Europavei 6 i Trøndelag og Mjøsregionen.
Regjeringens mål var å etablere et selskap som kunne bygge nye motorveier raskere og mer effektivt enn det de Statens vegvesen er i stand til. En analyse Nye Veier AS selv bestilte fra konsulentselskapet McKinsey konkluderte med at det koster nesten dobbelt så mye å bygge nye motorveier i Norge som i Sverige.
Fra den motsatte politiske siden har De Facto, et forskningssenter for deler av
fagbevegelsen, gått kraftig ut mot de borgerlige partienes satsing på nettopp Nye Veier AS.
Protestene har ikke ført frem og samferdselsminister Ketil Solvik-Olsen fortsetter med prosessen, der han hevder at Nye Veier AS vil gi en unik mulighet til «å tenke både langsiktig og helhetlig når det kommer til utbygging av motorveier».
Ikke mye handlingsrom
Som kjent var opprettelsen av Nye Veier politisk styrt. Men de sentrale tillitsvalgte i Vegvesenet ble involvert. Det betyr ikke at de kunne gjøre noe særlig fra eller til i prosessen.
– I hele den prosessen var vi sentrale tillitsvalgte involvert. Vi prøvde å gjøre det beste ut av situasjonen, men i realiteten var det en sak vi ikke fikk gjort noe særlig med, sier Jannike Hanssen, leder for fagforeningen Parat i Statens vegvesen.
Hun viser til E18-utbyggingen på strekningen Arendal-Grimstad der nesten alle som var i prosjektet i Statens vegvesen ble overført til det nye selskapet i og med at etableringen av Nye Veier AS ble vurdert til å være virksomhetsoverdragelse, ifølge lovverket.
– Vi fikk landet gode avtaler for de som ble overført med både permisjonsavtaler og pensjonsavtaler. Noen av de som ble overført har kommet tilbake til Statens vegvesen, men mange har valgt å bli, sier Hanssen.
Trafikkstasjoner i endring Vegvesenet har et pågående prosjekt kalt TK-Tjenestestruktur. TK står for trafikant og kjøretøy. Prosjektet omfatter både trafikkstasjonene og kundeservicesenteret i Vegvesenet i tillegg til funksjoner som utekontroll, i form av kontroll av kjøretøy langs veien.
Prosjektet omfatter også tilsyn, som handler om oppfølging av bilforhandlere, trafikkskoler og verksteder.
– Der ser vi blant annet på hvordan vi ville ha bygget opp Statens vegvesen i dag hvis vi skulle ha begynt helt på nytt, uten trafikkstasjoner? Derfor tror jeg ryktet har oppstått om at vi vil fjerne alle trafikkstasjonene. De kommer nok ikke til å forsvinne helt, men noen blir nok borte, sier Hanssen.
Dagens Vegvesen
- en kompetansepool
Statens vegvesen er organisert med ett Vegdirektorat samt fem regioner med en veiavdeling i hvert fylke i tillegg til fagavdelinger på regionveikontoret.
Både veiavdelingen og avdelingene på regionvegkontoret stiller sin organisasjon og fagkompetanse til disposisjon for den enkelte fylkeskommune i deres arbeid med utredning, planlegging, utvikling av kontraktsmaler, bygging, drift, vedlikehold og forvaltning av fylkesvei. Fylkeskommunene leder arbeidet med fylkesveisaker, som prioritering av tiltak, bevilgning av midler til fylkesveiene, tilsvarende det staten gjør på riksveiene.
Regionveisjefen rapporterer i fylkesveisaker til fylkeskommunen. For å løse mer kompliserte oppgaver innenfor eksempelvis tunnel, større bruprosjekter eller rassikring på en fylkesvei, kan regionveisjefen i den enkelte region trekke på spesialiserte kompetansemiljøer i andre veiregioner eller i Vegdirektoratet for å løse oppgaven i den enkelte fylkeskommune.
Statens vegvesen (Vegdirektoratet og regionene) utgjør med andre ord en samlet kompetansepool for den enkelte fylkeskommune. Regionvegkontorets arbeid for den enkelte fylkeskommune er regulert gjennom avtaler (flerårig rammeavtale og årlig leveranseavtale) mellom fylkeskommunen og regionvegsjefen.
Slik som Statens vegvesen har organisert sin virksomhet er det ingen faste organisatoriske enheter som bare utfører fylkeskommunale oppgaver. Videre får Statens vegvesen finansiert store
deler av utgiftene til veiadministrasjon over statsbudsjettet, slik at det for disse oppgavene ikke skilles mellom fylkeskommunale og statlige oppgaver i regnskapet. Det er ikke hele avdelinger som en kan peke på som skal overføres, men deler av oppgavene i en eller flere avdelinger
Skiller ut ansvar
På forsommeren i år behandlet Stortinget Regionreformen, som vil redusere antall norske fylker fra 19 til 11, inkludert Oslo. En rekke vedtak fulgte:
I forlengelsen av reformen ble det vedtatt en storstilt overføring av oppgaver fra statlig nivå til fylkene. Sykehus, barnevern, Innovasjon Norge, Forskningsrådet og viltforvaltning ble berørt.
I tillegg fattet Stortinget et vedtak som kan få stor betydning for drift av veier, og ikke minst for dem som jobber i veisektoren.


Vedtaket lød: «Stortinget ber regjeringen sørge for at regional veiadministrasjon, som har ansvar for planlegging og drift av fylkesveiene, overføres fra Statens vegvesen til regionalt folkevalgt nivå».
Nå arbeider Samferdselsdepartementet med et mandat som (trekk gjerne pusten her) vil gi Vegdirektoratet i oppdrag å utrede spørsmål om å overføre veiadministrasjonen som Vegvesenet utfører til fylkene etter veiloven.
Det er vel å merke ikke snakk om at regjeringen sender en melding til direktoratet med ordre om å overføre ansvaret, men en oppskrift på hvordan en slik prosess skal utredes.
Derfor er det for tidlig å si noe om hvordan en slik overføring i praksis vil arte seg, hvem som eventuelt må skifte arbeidssted, hva det kan bety for planlegging og drift av fylkesveiene og en lang rekke andre spørsmål.
Vi er alltid positive til effektivisering av offentlig forvaltning. Men i dette tilfelle føler vi at dette er en pulverisering av etaten vår.
Jannike Hanssen, leder for fagforeningen Parat i Statens vegvesen.
Det eneste vi kan driste oss til å slå fast er at omleggingen blir stor, og viktig. Det bekreftes av de tillitsvalgte.
– Dette er veldig viktig. For dette kommer til å berøre alle som jobber i Statens vegvesen, og med nesten 700 medlemmer totalt i Parat Statens vegvesen, så vil dette berøre mange av våre medlemmer, sier Hanssen.
– Hvor stor del av Vegvesenets virksomhet er i dag knyttet til den virksomheten som blir berørt?
– Dette er et veldig vanskelig spørsmål å svare på. For en person som for eksempel jobber på veiavdelingen jobber ikke 100 prosent med fylkesveier. Vedkommende
jobber også for eksempel med riksveinettet, sier Hanssen.
Hvorfor forandre på noe som fungerer? Regionreformen har som mål å gi en rekke positive effekter, ikke minst å effektivisere offentlig forvaltning. Hanssen er positiv til effektivisering, men advarer likevel mot å reparere noe som allerede virker.
– Vi er alltid positive til effektivisering av offentlig forvaltning. Men i dette tilfelle føler vi at dette er en pulverisering av etaten vår. Vi har i mange år stått for planlegging og drift av fylkesvegene og har hatt et godt samarbeid med fylkene ute, så hvorfor endre på dette når ting fungerer, spør Hanssen.
– Kommer det til å forsvinne arbeidsplasser i Statens vegvesen?
– Det sier seg selv at det kommer til å forsvinne folk fra Statens vegvesen. Vi jobber ennå med å utrede om det kan dreie seg om en virksomhetsoverdragelse eller ikke, sier den Parat-tillitsvalgte.
Hanssen sier at dersom denne overføringen av ansvar ikke skulle bli vurdert som en virksomhetsoverdragelse i juridisk forstand, så kan det nesten se ut som ansatte i Statens vegvesen må søke på «sin egen jobb» i fylkene.
– Det dreier seg ikke bare om de ansatte som jobber på veiavdelingene, men vi har ansatte i flere avdelinger som også jobber med fylkesveiene, sier hun.
– Men det vil vel i så fall kanskje kompenseres av at behovet for den samme kompetansen vil øke i fylkeskommunene?
– Kompetansen vil øke i fylkeskommunen og kanskje forsvinne fra Statens vegvesen, sier Hanssen.
– Jeg forstår at det er for tidlig å si konkret hvordan dette vil arte seg, men vet vi hvilke funksjoner som skal overføres?
I stortingsvedtaket heter det jo at «regional veiadministrasjon, som har ansvar for planlegging og drift av fylkesveiene, overføres fra Statens vegvesen». Gir dette en indikasjon på hva som skal overføres og ikke?
– Situasjonen vil ofte være slik at ansatte både har statlige og fylkeskommunale arbeidsoppgaver, oppgavene vil kunne flyte over i hverandre, og mengden oppgaver for den ene eller den andre vei-eier vil kunne variere sterkt over tid. Så det er noe uklart, hva og hvilke funksjoner som skal overføres.
– Hvordan oppfatter du stemningen og holdningene ute blant medlemmene til det som skal skje?
– Holdningen er nok slik at dette er ting de ikke får gjort noe med i og med at det er politisk styrt, men de er bekymret for arbeidsplassene sine. Stemningen er nok også litt avventende til vi får mer fakta på bordet, sier Hanssen.
– Hva gjør dere med saken?
– Vi som er tillitsvalgte på sentralt nivå har møter med ledelsen cirka en gang i måneden, i tillegg til at dette står fast på agendaen til alle hovedavtalemøtene. Ute i regionene driver de nå med kartlegging av ressursene vi bruker på fylkesvegene, sier hun.
Hanssen sier at de tillitsvalgte blir løpende informert om fremdriften i prosessen av ledelsen i Statens Vegvesen.
Hull i tennene?
Sprukne fyllinger?
Rotfylling?
Nå kan du få dekket utgifter til tannbehandling. Som YS medlem får du tannhelseforsikring til en svært god pris.
Sjekk hva du betaler i måneden:
• 18–29 år: 47 kroner
• 30–49 år: 106 kroner
• 50–69 år: 170 kroner
Les mer og kjøp YS Tannhelseforsikring på norsktannhelseforsikring.no/ys
Grunnopplæringen Trinn1-kurs og Trinn2-kurs avholdes regionalt, for å bli kjent og bygge nettverk med andre i din region. Trinn3-kurs avholdes på østlandsområdet og følger avtaleverket, kursene er tilpasset de ulike sektorene (privat, stat, kommune og Spekter). Vi har videre delt opp Trinn3-kursene i følgende sektorer: Statlig sektor, privat sektor og Spekter (1-9) og KS, Virke-Huk og Spekter helse. Er du usikker på hvilken sektor du tilhører kan du gå inn på parat.com og finne dette på «Min side», der du finner din egen tariffavtale.
Fordypningskursene er tilrettelagt for at tillitsvalgte skal få økt kompetanse innenfor de områdene som er viktige i vervet som tillitsvalgt på arbeidsplassen. De aller fleste fordypningskursene krever gjennomført grunnopplæring i Parat, eller tilsvarende forkunnskaper.
Høgskolekursene arrangerer vi i samarbeid med Høgskolen i Sørøst-Norge. Tillitsvalgte kan ta ett høgskolekurs hvert kalenderår. Våren 2018 arrangeres «Grunnleggende arbeidsrett» og høsten 2018 arrangeres «Samfunnsfag», med vekt på politikk og flerkulturelle samfunn.
Forelesninger på nett
Webinar er forelesninger på nett, med direkte overført bilde og lyd, i tillegg er det lagt til rette for chat, der du fortløpende kan stille spørsmål og få svar. Foreløpig er webinar, eller nettmøter i utprøvingsfasen her i Parat, men dette vil det blir mer av i 2018.

Kurspyramiden for tillitsvalgte i Parat
Eksamenskurs
Grunnopplæring Fordypningskurs

Fikk du ikke invitasjon til kurset?
I god tid før kursstart får tillitsvalgte en e-post med kursinvitasjon. Opplysningene hentes fra Parats medlemsregister. Men hvis du ikke er registrert med riktig verv eller riktig e-postadresse, vil du ikke få invitasjon. Du kan selv rette opp dine personopplysninger i medlemsregisteret, men for å få registrert riktig verv må du kontakt ditt regionkontor.
15.–17. januar Presentasjonsteknikk og kommunikasjon, Sanner 22.–24. januar Trinn3-kurs stat, Sanner 22.–24. januar Trinn3-kurs privat og Spekter (1-9), Sanner 22.–25. januar Grunnleggende arbeidsrett 15. studiepoeng 1. samling, Scandic Oslo City
5.–7. februar Trinn2-kurs Øst og Sør (tilpasset KS), Quality grand hotel, Kongsberg
5.–7. februar Kurs i forhandlingsteknikk privat sektor og spekter, Sanner
12. februar Paratkonferansen, Scandic Oslo airport
13. februar Tariffkonferansen, Scandic Oslo airport
14.–16. februar Forhandlingsteknikk og lokale forhandlinger KS/Virke-Huk og Spekter helse, Olavsgaard
26.–28. februar Presentasjonsteknikk og kommunikasjon, Sanner
5.–7. mars Økonomiforståelse og lokale forhandlinger i privat sektor og spekter, Scandic Oslo Airport
12.–14. mars Forhandlingsteknikk stat, Scandic Oslo Airport
13.–15. mars Trinn2-kurs Midt og Nord, Scandic Ishavshotel 13.–15. mars Trinn2-kurs Vest, Quality hotel Edvard Grieg 20.–23. mars Grunnleggende arbeidsrett 15. studiepoeng 2. samling, Scandic Oslo City
17.–18. april Styrearbeid, Olavsgaard
23.–25. april Konflikthåndtering, kommunikasjon og juss., Scandic Oslo Airport
24.–26. april Trinn2-kurs Øst og sør, Quality Hotell Klubben
23.–25. mai Trinn3-kurs privat og spekter (1-9), Sanner
4.–5. juni ParatStat konferansen, Radisson Blu, Gardermoen
29.–31. august Trinn2-kurs Øst og Sør, Olavsgaard
30. august Lokale forhandlinger for funksjonærer i NHO og Virke, Parats lokaler
3. september Tilsettingsråd stat, Park Inn
5.–6. september Regionmøte Vest, Bergen
10.–11. september Regionmøte Øst 12.–13. september Regionmøte Midt 17.–19. september Trinn3-kurs stat, Olavsgaard 17.–20. september Samfunnsfag – med vekt på politikk og flerkulturelle samfunn, Scandic Oslo City
20.–21. september Regionmøte Nord
26.–27. september Regionmøte Sør
15.–17. oktober Trinn2-kurs Øst og Sør (tilpasset KS), Kongsberg
16.–18. oktober Trinn2-kurs Vest, Quality Hotel Edvard Grieg
17.–18 oktober Arbeidsgivers styringsrett, omstilling, permittering og nedbemanning - privat, Olavsgaard
22.–23 oktober Retorikk, Olavsgaard
23.–25. oktober Trinn2-kurs midt og Nord, Quality hotel Augustin
1.–2 november Arbeidsgivers styringsrett, omstilling og nedbemanning, Olavsgaard
5.–7. november konflikthåndtering - kommunikasjon og juss., Olavsgaard
14.–15. november Parat Landsmøte 2018, Radisson Blue, Bergen
20.–22. november Trinn2-kurs Øst og Sør, Quality grand hotel, Kongsberg
20.–22. november Trinn3-kurs KS, Virke-Huk, spekter helse, Olavsgaard
26.–27 november Retorikk, Olavsgaard
28.–30. november Trinn3-kurs Privat og spekter (1-9), Sanner
28.–30. november Trinn3-kurs stat, Sanner
3.–4 desember Arbeidstid, Olavsgaard
Parat ønsker å bruke opplæringsmidlene til gode kurs med mye læring på anerkjente hotell. For at flest mulig deltakere skal rekke fram samme dag, starter derfor de fleste kursene klokken 11.00. Ved å unngå overnatting dagen før kursstart og unødig bilgodtgjørelse, vil flere få anledning til å delta på kurs. Reisen må foregå på rimeligste måte og vi henviser til Parats reiseregulativ på Parats hjemmesider.
Parat har i de siste årene dessverre hatt mange ubenyttede hotellrom, uten at deltagerne har gitt beskjed eller meldt avbud. Dette hindrer at personer på venteliste får plass. Deltakere som uteblir fra et arrangement med bestilt overnatting, uten å varsle Parat, vil derfor i 2018 få tilsendt en regning på 1000 kroner pr. natt.
For Parat-kurs som blir avholdt på Sanner hotell, anbefaler vi deltakere fra Oslo å ta tog til Gran stasjon (på Gjøvikbanen). For deltakere som kommer fra Gardermoen, settes det opp en felles taxi fra flyplassen, bestilt av Parats kursadministrasjon. Det er viktig at deltagere på disse kursene gir tilbakemelding på om man skal være med eller ikke innen fristen som er oppgitt. Ved forsinkelser, må kursdeltager ta kontakt med kursansvarlig. Man må ikke benytte taxi alene uten godkjenning fra Gardermoen til Sanner.
Målgruppen på kursene er tillitsvalgte i Parat. Vi sender ut kursinvitasjon elleve uker før kursstart til tillitsvalgte som er i målgruppen for kurset. Deltakere på kurs blir valgt ut i fra verv, og hovedtillitsvalgte vil bli prioritert. For at du skal bli prioritert som kursdeltaker er det viktig at informasjonen på «Min side» til enhver tid er oppdatert.
For å kunne komme inn på «Min side» og melde deg på kurs, må du ha medlemsnummer og passord. Der står det også hvilke kurs og konferanser du har deltatt på tidligere og hvilke du har fått plass på. Har du spørsmål, ta kontakt med medlem@parat.com.
Har du spørsmål til kursene, kontakt: kurs@parat.com, eller ring sentralbord på telefon: 21 01 36 00.
Du kan også kontakte kursadministrasjon i Parat direkte:
• Hege Thorud, e-post: hege.thorud@parat.com, telefon: 924 49 819
• Monica Bjørlo, e-post: monica.johansen.bjorlo@parat.com, telefon: 930 40 952
• Bente Trøen, e-post: bente.troen@parat.com, telefon: 909 72 832
Øvrig
Regionene arrangerer Trinn1-kurs og konferanser for tillitsvalgte. For medlemmene tilbyr regionskontoret faglige temadager og aktiviteter av sosial karakter. Har du spørsmål om dette, kan du kontakte ditt regionskontor.
For mer informasjon om Parats kurs, konferanser, temadager og andre aktiviteter, finner du dette på parat. com, se «kurs og utdanning».


Parat-medlem Jan Erik Aasen er skadedyrbekjemper i ABS Skadedyrkontroll. Foto: Vetle Daler.

Hjemme har han en blind katt med diabetes. På jobben tar han livet av småkryp. Møt skadedyrbekjemper og Parat-medlem Jan Erik Aasen en dag han jakter skadedyr i en enebolig på Nesbru i Asker utenfor Oslo.
Av: Vetle Daler
En kunde har ringt og klaget på at det kravler i taket på soverommet. Da rykker
Jan Erik Aasen (48) ut. Han er skadedyrbekjemper i ABS Skadedyrkontroll, og er ukentlig på oppdrag hos kunder i Oslo-området.
Giftig møte
Denne høstfredagen tar han runden rundt huset på Nesbru og sjekker boksene med gift han har satt ut tidligere.
– Boksene er til for å få ned bestanden, det er ikke løsningen. Løsningen er å finne ut
hvor de kommer seg inn i huset, og tette sprekkene, sier han.
Han bytter ut giftblokkene som mus og rotter har forsynt seg av, og flytter noen av boksene til andre steder på eiendommen

15 ansatte som opererer i Oslo og resten av Sør- og Østlandet.
• Betjener bedrifter, institusjoner, næringsmiddelbedrifter, hoteller, restauranter og kafeer, dagligvareforretninger og private hjem.
• Jobber med bekjempelse og forebygging av insekter, rotter, mus og lagervareinsekter, duekontroll og hygienekontroll av næringsmiddelbedrifter
Aasen bytter ut giftblokkene som mus og rotter har forsynt seg av. Foto: Vetle Daler.
før turen går inn i huset. Blant stedene som sjekkes er under kjøkkenbenken, hvor gnagere ofte dukker opp for å lete etter mat.
– Ingen spor her, men det har hendt at jeg har funnet musereir under kjøkkenbenker, sier Aasen.
For å bli godkjent skadedyrbekjemper må det kurs og eksamen til, i regi av Folkehelseinstituttet.

– Her må man blant annet være i stand til å gjenkjenne 20 ulike skadedyr, sier Aasen.
Blant dyrene en skadedyrbekjemper må ha kompetanse på er maur, biller, veggedyr, flått, veps, humle, bier, fluer, kakerlakker og forskjellige gnagere som rotter og ulike typer mus.
Jobben som skadedyrbekjemper er sesongbetont.
– Vi er ute på oppdrag hele året, men det er ekstra mye på høsten, særlig når det begynner å bli kaldt og snøen kommer. Da søker gnagerne inn, sier Aasen.
Han forteller historien om kunden som hadde et lager med proteinpulver i kjelleren.
– En rotte hadde kommet seg inn og forsynt seg av pulveret. Den var så stor til slutt at den ikke kom seg ut. Det var en ordentlig sværing, ler Aasen.


Humant og effektivt
Til tross for at jobben hans er å utrydde uønskede småkryp, er Aasen glad i dyr. – Jeg er veldig dyrekjær, og er opptatt av avliving skal gjøres så humant og effektivt som mulig. De er jo levende vesener. Rotter og mus er faktisk også beskyttet av dyrevelferdsloven, sier han.
Hjemme på Vøyenenga i Bærum har han en katt som er blind på det ene øyet, og som i tillegg har diabetes.
– Jeg har vært mye hos veterinæren med katta, og da er det greit å ha en jobb der jeg har frihet under ansvar. Jeg styrer det meste av tiden min selv, sier Aasen.
I tillegg til å bekjempe skadedyr «i felten», bestyrer han nemlig ABS’ egen nettbutikk.

1. Blant stedene som sjekkes er under kjøkkenbenken, hvor gnagere ofte dukker opp for å lete etter mat. Foto: Vetle Daler.
2. Det hender han finner musereir under kjøkkenbenker. Foto: Vetle Daler.
3. Aasen har ansvaret for nettbutikken, der firmaet selger «gjør det selv»-produkter for skadedyrbekjempelse. Foto: Vetle Daler.

– Opprinnelig er jeg utdannet bilmekaniker, men har mange års bakgrunn fra lager, logistikk og innkjøp. Derfor var det naturlig at jeg fikk ansvaret for nettbutikken, hvor vi selger «gjør det selv»-produkter for skadedyrbekjempelse. Vi startet nettbutikken for halvannet år siden og omsetter allerede for seks millioner kroner, så her er det et stort marked, sier Aasen.
Vepsejobber
Aasen trives godt med å drive nettbutikken, men setter også pris på uteoppdragene. Og noen jobber er morsommere enn andre.
– Vepsejobber synes jeg er ganske artig, der er det mye rart. Ofte tør ikke kundene å fjerne vepsebol selv, spesielt de som er
redde for allergiske reaksjoner ved stikk. Så da er det bare å utstyre seg med drakt og ansiktsbeskyttelse og sette i gang. Jeg har vært forskånet fra å få vepsestikk på jobb, men en kollega fikk veps innunder drakta, humrer han.
– Visste du forresten at det er en myte at vepsen bare stikker en gang?
Bier, derimot, stikker bare en gang. I disse tider hvor bie-bestanden synker, er Aasen og kollegaene hans forsiktig med å drepe bier.
– Vi prøver heller å flytte dem, men i noen tilfeller, der de er en stor plage, må man drepe dem. Vi prøver alltid å overtale kunden til å finne andre løsninger først, sier han.

Veggdyr øker
De siste årene har antallet «eksotiske» skadedyr som kakerlakker og veggedyr økt i Norge.
Fra 2007 til 2016 har antall registrerte årlige veggedyrbekjempelser økt med nærmere 700 prosent. I 2007 ble det registrert 447 bekjempelser av veggedyr i Norge. Ni år senere, i 2016, ble det notert 3034 tilfeller. Rundt 30 prosent gjelder overnattingssteder, ifølge Folkehelseinstituttet. – Får du veggedyr, må alt ut, klær, tekstiler og møbler. Møblene plasserer vi på fryselager i noen dager. Mange kaster faktisk sengene sine etter veggdyrangrep, sier Aasen.
Når du er på reise bør du ifølge Aasen sette kofferten i badekaret, og skifte klær på badet.
– Ikke la klær ligge og slenge på hotellrommet. Du kan også vippe opp senga og lyse med lommelykt for å se etter svarte flekker. Finner du slike flekker, er det trolig avføring fra veggedyr. Når du kommer hjem, bør du pakke ut utendørs og fryse ned klærne du har hatt med deg før du vasker dem. Det er litt styr, men får du veggedyr inn, kan jeg love deg at det blir mer styr, og det kan bli dyrt. Enkle forholdsregler kan spare deg for mye, sier han.
Ta forholdsregler
Skadedyrbekjemperen har også flere tips for hvordan du kan unngå de mer «tradisjonelle» skadedyrene.
– Ikke mat fugler for nær huset. Driver du med kompost, bruk en lukket kompost-
han.
og hold vegetasjon
Du kan også ifølge Aasen ta en runde rundt huset med speil eller selfiekamera, se under panelet etter sprekker der gnagere kan komme seg inn.
– La heller ikke vedstabler og lignende stå inntil husvegger. Når det gjelder maur, bør du ikke ha jord inntil veggen. Du bør også fjerne gamle stubber og råtne trær i nærheten, sier Aasen.


Parats hovedstyre har tidligere vedtatt at flaggsaken for 2018 skal være «Arbeidstid for fremtiden», noe som gjør at dette temaet vil synliggjøres i mye av arbeidet som skal gjøres i tiden fremover.
Noe av det organisasjonen vil sette søkelys på er positive og negative konsekvenser, i endret arbeidstid, som følge av den teknologiske utviklingen. I dette ligger også synliggjøring av hvilke positive og negative konsekvenser økt fleksibilitet i arbeidslivet har for forholdet mellom arbeidstid og fritid.
Parats medlemmer i Agility
Subsea Fabrication i Tønsberg får tariffavtale etter en tvist mellom Parat og NHO. Paratmedlemmene blir omfattet av Verkstedoverenskomsten.
Selskapet legger ned driften i Skien og flytter ansatte til verftet i Tønsberg. NHO ønsket å vente til denne sammenslåingen var gjennomført før de ansatte kunne få tariffavtale, men Parat var av en annen mening. – Kollektive forhandlinger er en forutsetning for at det organiserte arbeidsliv skal fungere. Det er gjennom tariffavtalen de tillitsvalgte får forhandlingsrett på vegne av medlemmene og rett til informasjon og drøftelser med arbeidsgiver, sier Parats forhandlingssjef Turid Svendsen.

Svendsen. Foto: Vetle Daler.

Maren Hestenes Merli er advokat og ansatt i et tre måneders vikariat i Parats juridiske avdeling. Hun har jobbet i advokatfirmaet Grette, der hun fikk advokatbevilling i februar 2017. I Grette har Hestenes Merli jobbet med arbeidsrett og vil fortsette i 20 prosent stilling der, mens hun vikarierer de resterende 80 prosent i Parat.
Siren Somby er ansatt som rådgiver på Parats regionkontor i Tromsø fra januar 2018. Hun har en master i inno vasjon, organisasjon og ledelse fra Norges Fiskerihøgskole og har tidligere jobbet i NHO. I NHO jobbet Somby med kurs i arbeidsrett, varsling, HMS, medietrening og coaching.

Truls O. Bjørhei er ansatt som rådgiver på Parats regionkontor i Oslo fra januar 2018. Han er utdannet jurist (cand.jur) og har jobbet i NAV. Bjørhei har tidligere vært tillitsvalgt i AVYO og vil særlig jobbe med statsansatte og medlemmer i kommunal sektor.

Nathalie Gullager er ansatt i et vikariat i Parats regionkontor i Oslo fra februar 2018. Hun har en bachelor i jus og en mastergrad i menneskerettigheter og mul tikultur. Gullager har jobbet administrativt i Norwegian og som frivillig i Røde Kors og Amnesty. Hun har tidligere vært tillitsvalgt i forbindelse med studiene.

Du kan spare mye ved å bruke Parats medlemsfordeler og nyte godt av noen av markedets beste forsikringer. Vi har også gode låne- og spareavtaler.
Som medlem får du direkte tilgang til en rekke advokater med spesialkompetanse, der arbeidsrettslig bistand er gratis. Du kan i tillegg få en times gratis konsultasjon med advo kat i privatrettslige saker. Rabatt på hotell, leiebil, drivstoff og strøm er andre fordeler du har tilgang til, se parat.com for detaljer og mer informasjon.

RU region Nord (Finnmark, Troms, Nordland): Leder: Lars Raymond Holm, Luftfartstilsynet E-post: Lrh@caa.no
Johanne Hagerupsen, Høgskolen i Harstad E-post: johanne.hagerupsen@hih.no
Anne-Katrine Thomassen, Brønnøysundregisterne E-post: akt@brreg.no
Tor-Fredrik Olsen, Finnmark Fylkeskommune E-post: tor.fredrik.olsen@ffk.no
Åse Helen Andersen, Apotek 1 Hammerfest E-post: aasehelande@hotmail.com
Terje Grytdal Roland, Nord-Troms Tingrett, UNG-representant E-post: terje.grytdal.roland@domstol.no
RU region Midt (Nord- og Sør Trøndelag, Møre og Romsdal): Leder, Jannike Hanssen, Statens vegvesen E-post: Jannike.hanssen@vegvesen.no
Morten Mørch, NTNU E-post: Morten.morch@ntnu.no
Siri Finseth, Helse Nord-Trøndelag E-post: Sirs.finseth@helse-nordtrondelag.no
Grete Kambuås, Boots Apotek E-post: gretkam@online.no
Marit Holstad Aarsæther, Høgskolen i Volda E-post: maritaa@hivolda.no
Mona Nerland, Politiet i Molde, UNG-representant E-post: mona.nerland@politiet.no
RU region Øst (Østfold, Hedmark, Oppland, Oslo og Akershus):
Leder: Hilde Margrete Bjørklund - Cappelen Damm AS E-post: hilde.bjorklund@cappelendamm.no
Bente Iren Tollefsen Moen - Statens Pensjonskasse E-post: bente.iren.moen@spk.no
Stein Grindheim - SAS Ground Handling E-post: stein.grindheim@sas.no
Ronny Kjønsø - Asko Øst E-post: ronny.kjonso@asko.no
Anja P. Ahlstrøm – NIBIO E-post: Anja.Ahlstrom@nibio.no
Hans Andreas Bøhmer, Securitas i Oslo, UNG-representant E-post: hanboh@gmail.com
RU region vest (Rogaland, Hordaland, Sogn og Fjordane):
Leder: Rune Skaar, Bergen kommune E-post: rune.skaar@bergen.kommune.no
Vidar Alfei, NAV Økonomitjeneste E-post: vidar.alfei@nav.no
Hege Solbakken Sæbø, Stavanger Aftenblad AS E-post: hege.solbakken.saebo@aftenbladet.no
Wibecke Søraas Onarheim, Gulating lagmannsrett E-post: wibecke.soraas.onarheim@domstol.no
Gro Nondal Buvik, Sognekraft AS E-post: gro.nondal.buvik@sognekraft.no
Erik Andreassen, Gate gourmet i Bergen, UNG-representant E-post: eandreassen@gategourmet.com
RU region Sør (Aust- og Vest Agder, Telemark, Vestfold og Buskerud):
Leder: Ragnhild Negård – NAV E-post: ragnhild.negard@nav.no
Nina Ødegård – Høyskolen i Buskerud og Vestfold
E-post: Nina.Odegard@hbv.no
Cecilie Holt, NAV
E-post: cecilie.holt@nav.no
John-Inge Nerland – Fylkesmannen i Buskerud
E-post: fmbujin@fylkesmannen.no
Anne Britt Skomedal, Vitusapotek Elefanten Kristiansand E-post: annebritt1962@hotmail.com
Lahvry Helene Fürst Bright, UNG-representant
E-post: lahvry@hotmail.com
Spørsmål til juridisk og forhandlingsavdelingen i Parat
Vi som gir svar i denne utgaven av Parat er:

Are





Har du spørsmål til juristene eller til forhandlingsavdelingen, kan du sende spørsmålene til trygve.bergsland@parat.com. Vi hjelper deg som medlem med alle typer problemstillinger knyttet til arbeidsforhold og tolkning av avtaleverket. Du kan også ta kontakt med oss når det er behov for skriftlig og muntlig rådgivning i forbindelse med omorganisering, nedbemanningsprosesser, ferie, arbeidstidsordninger, trygdespørsmål og lignende.
For liten lønnsøkning
Vi har akkurat hatt lokale lønnsforhandlinger i kommunen hvor jeg jobber. Jeg er ikke fornøyd med det tillegget jeg fikk. Selv om jeg vet at vår tillitsvalgt gjør så godt hun kan i forhandlingene, vil ikke arbeidsgiver prioritere meg. Har du noen gode råd?
Wenche
Svar: Det vil alltid være slik at ikke alle får innfridd sine forventninger i lønnsforhandlingene. Pengene som skal fordeles er begrenset. I hovedtariffavtalen har vi bestemmelsen om lønnssamtale, der du kan be om en samtale med din nærmeste leder for å diskutere din lønnsutvikling. Her kan du også diskutere arbeidsgivers forventninger til din jobbutførelse og hva som skal til for å få
en bedre lønnsutvikling. Hvis du ønsker, kan du ha din nærmeste tillitsvalgt med i møtet og det skrives referat fra møtet dersom du ønsker det.
Bjørn Are
Oppsigelse og nye ansettelser Jeg har vært ansatt i et transportfirma som i sommer måtte gå til oppsigelse av fem fordi vi mistet en stor kunde.
Oppsigelsesprosessen foregikk på en korrekt måte og arbeidsgiver fulgte ansiennitetsprinsippet og vi med kortest ansiennitet ble sagt opp. Nå er det snakk om at arbeidsgiver har avtale med en ny kunde, og at det er behov for å ansette tre av oss igjen. Spørsmålet mitt er om arbeidsgiver står fritt til å velge hvem av oss han vil ansette?
Svar: En arbeidstaker som er sagt opp på grunn av driftsinnskrenkning har fortrinnsrett ved nyansettelse. Fortrinnsretten gjelder i et år fra oppsigelsestidens utløp. Dersom det er flere som har rett til en stilling, plikter arbeidsgiver å følge de samme reglene for utvelgelse ved oppbemanningen som ved den forutgående nedbemanningen. Dette er beskrevet i arbeidsmiljølovens paragraf 14-2. Bestemmelsen innebærer at arbeidsgiver plikter å legge de samme utvelgelseskriteriene til grunn ved inntak som ved oppsigelsene. Dersom ansiennitetsprinsippet ble fulgt ved oppsigelsene, er arbeidsgiver som hovedregel forpliktet til å følge det samme prinsippet ved oppbemanningen. Dersom kompetansebehovet er et annet enn på oppsigelsestidspunktet, kan det imidlertid være saklig grunnlag for å fravike ansiennitetsprinsippet ved nyansettelse.
Anders
Omsorgspermisjon
Jeg har en gammel og syk mor på 93 år, som ved enkelte undersøkelser på sykehus trenger følge av pårørende. Er det noen bestemmelser som gir meg rett til fri for å følge henne når det er nødvendig?
Rigmor
Svar: Ja, i henhold til arbeidsmiljølovens bestemmelser har alle arbeidstakere rett til permisjon i inntil ti dager hvert kalenderår for å gi nødvendig omsorg til foreldre,
ektefelle, samboer, eller registrert partner. Arbeidsmiljølovens bestemmelse regulerer kun rett til fri og ikke rett til fri med lønn. Dersom du er omfattet av en tariffavtale vil eventuelle rettigheter til velferdspermisjoner med lønn være regulert der. Alternativt kan også retningslinjer eller praktisering av velferdspermisjoner være beskrevet i bedriftens personalhåndbok.
Renate

Betaling for ubekvem arbeidstid Jeg jobber en del ubekvem arbeidstid og får normalt utbetalt tillegg for dette. Nå krever arbeidsgiver at jeg skal avspasere ubekvem arbeidstid og at jeg ikke kan kreve å få utbetalt dette som lønn. Er dette riktig?
Turid
Svar: I henhold til arbeidsmiljølovens paragraf 10-6 (12) er det slått fast at tillegg for arbeidet overtid ikke kan avspaseres, men må utbetales som lønn. Det finnes ikke tilsvarende lovbestemmelse for ubekvemstillegg eller skifttillegg. Svaret avhenger derfor av hva som er avtalt. Arbeidsgiver kan ikke uten skriftlig avtale pålegge avspasering av ubekvemstillegget, og du kan heller ikke kreve å avspasere med mindre det er avtalt. Slike avtaler kan bare inngås med den enkelte arbeidstaker.
Det vil si at en avtale mellom arbeidsgiver og tillitsvalgte om at ubekvemstillegg skal avspaseres, ikke vil være gyldig. Oppsummert vil du altså ha krav på å få kompensasjonen for ubekvem arbeidstid utbetalt som lønn med mindre du har avtalt noe annet.
Thomas
Bytte av julegaver
Jeg bruker å få mye «ræl» til jul, og jeg begynner å bli lei av alt som fyller opp skuffer og skap. Det er også et styr å få skrotet på loppemarked hvert år. Hva kan jeg gjøre for å få byttet presangene til noe som jeg har glede og nytte av? Kan jeg kreve det av den butikken gaven er kjøpt?
Truls Reidar
Svar: Kanskje du bør ta en prat med slektningene dine og andre du får gaver fra. Fortell dem hva du ønsker deg. Du kan også be om at byttelapp legges ved. Etter kjøpsloven eller forbrukerkjøpsloven har du ikke krav på å få byttet varen, men mange butikker åpner for bytting i romjulen og ut på nyåret. Dette forutsetter som oftest at varen er som ny og i originalinnpakning. Noen gir penger tilbake, men de fleste butikker gir deg en «tilgodelapp» som du kan bruke på andre varer i samme butikk.
Thore
Ferie til gode når året er slutt Jeg har ikke rukket å ta ut all ferien min i år, hva gjør jeg?
Beate
Svar: Du må ta opp dette med arbeidsgiver. Utgangspunktet er at all ferie skal avvikles i ferieåret. Det er imidlertid adgang til å avtale overføring av ferie. Det er maks tolv dager ferie, av den lovbestemte ferien på 25 virkedager, som kan flyttes til året etter slik som beskrevet i ferielovens paragraf 7 (3).
Avtale om overføring av ferie må gjøres skriftlig. Dersom du har avtale om rett på «den femte ferieuka» kan denne også avtales overført i tillegg til de tolv dagene som beskrevet over. Det er ingen formkrav for avtale om overføring av denne ferien, men vi anbefaler skriftlig avtale av bevishensyn. Dersom du ikke får lov å overføre ferie må du ta ut ferien i år. Arbeidsgiver har styringsrett på når den skal plasseres, men dere skal forsøke å bli enige først.
Guro

Løsningen på kryssordet i medlemsbladet Parat nummer. 4 – 2017 var: «UTSIKT OVER LYSEFJORDEN». Den heldige vinneren er: Beate Borge, Tromsø. Frist for å sende inn løsning på neste kryssord er: 5. februar 2018.
Vi trekker én vinner hver gang. Send løsningen til redaksjonen, enten som e-post til trygve.bergsland@parat.com eller ordinær post til: Parat, Postboks 9029, Grønland, 0133 Oslo
Løsning:
Navn:
Adresse:
Husk å merke e-posten/konvolutten «Kryssord 5/2017» Husk også å skrive på ditt eget navn og adresse.
Premie: Elvang Latitude alpakka-pledd av 50 prosent alpakkaull, 40 prosent fåreull og 10 prosent mikrofiber. Pleddet er Fair Trade-sertifisert. Målene er 130x200 centimeter (se foto).

Vannrett
1. Guttenavn
7. Høytid
8. Pikenavn
9. Gass
11. Raptus
12. Karakter
14. Rusmiddel
16. Studio
19. Folkerekke
20. Fase
21. Skjoldmø
24. Rekker
Loddrett
1. Bedrager
2. Besøkende
3. Jaktbytte
4. Pikenavn
5. Om
6. Razzia
10. Sportslig begivenhet
13. Fiende
15. Flatemål
17. Rørlig
18. Renomméet
22. Er nødt til 23. Tresort
Alle feltene skal fylles med tall. Noen tall er fylt inn på forhånd, og dette utgjør summen av tallene i de to feltene under. Du må sette inn begge tallene i de to tilstøtende feltene for å finne tallet i feltet over, og motsatt, du finner tallet i et felt ved å trekke tallet i feltet ved siden av fra tallet i feltet over.
Lett Middels
Bokstavene i ordet under har blandet seg litt. Kan du nne fram til riktig ord ved å plassere bokstavene i riktig rekkefølge i de hvite feltene?
Den grå teksten på siden gir deg noen hint. Skjul teksten om du ikke vil ha hjelp.
Ordet starter med bokstaven A Foretaksomhet Virketrang FYLL INN ORDET:
SVAR:
AK TIVITET
Vanskelig
Finn alle ordene. Ordene kan stå vannrett, loddrett eller diagonalt, og kan ofte stå skrevet baklengs.
BARRIEREREV BENTSEN BEUNDRERINNE DRIFTSBYGNING FERMATE FINKARDING LIVSELIKSIR OLJEMANGEL OMRINGNING SAMLINGSMØTE SAMMENSNEKRA
SKJENDIG SØRPOL TILBAKELEVERE UTALANDSK
PARATS TRENINGSSIDE MED HJERNETRIM
Sender du oss løsningen på alle oppgavene på denne siden, er du med i trekningen av en Elvang Latitude alpakka-pledd av 50 prosent alpakkaull, 40 prosent fåreull og 10 prosent mikrofiber. Pleddet er Fair Tradesertifisert. Målene er 130x200 centimeter (se foto).

Frist for å sende inn løsningen er 5. februar 2018. Vi trekker én vinner hver gang. Send løsningen til redaksjonen, enten på e-post til trygve. bergsland@parat.com, eller ordinær post til: Parat, postboks 9029 Grønland, 0133 Oslo. Husk å merke e-posten/konvolutten «Hjernetrim 5/2017». Vinneren av hjernetrim i 4/2017 er Patricia Patoka, Oslo.
Parat er både gjennom YS og direkte, medlem av internasjonale organisasjoner som jobber for arbeidstakere innenfor ulike bransjer og sektorer der vi har medlemmer. Det er flere årsaker til at vi er medlem og betaler kontingent til disse.
Det viktigste er solidaritet og ansvaret vi har for å bidra til at også arbeidstakere i andre deler av verden kan forbedre sine arbeidsvilkår. En mer egoistisk årsak er at vi ved å bidra til så gode vilkår som mulig i andre land, kan motvirke press på vilkårene for arbeidstakere i Norge.
Nylig var jeg med i en YS delegasjon til verdenskongressen i Public Services International (PSI). Over 800 delegater fra hele verden møttes i Genevè for å diskutere felles utfordringer og hva vi kan gjøre med disse. Hovedinntrykket fra denne kongressen er at utfordringene for offentlige ansatte og borgerne disse er satt til å hjelpe, er store mange steder i verden. Der Norge er en velferdsstat som bruker både skatteinntekter og inntekter fra naturressurser på velferd, er situasjonen en helt annen i mange andre land. Ikke bare er det lite skatteinntekter som går tilbake til befolkningen i form av offentlige tjenester, men de pengene som går til dette formålet handler ofte i lommene til noen få som følge av korrupsjon og annen økonomisk kriminalitet.
PSI kongressens hovedtema «Velg folk fremfor profitt», er naturlig når vi vet at den nederste halvparten av verdens befolkning eier mindre enn én prosent av den totale rikdommen, mens den rikeste topp ti prosenten eier 89 prosent av alle globale eiendeler.
Brytes tallene enda mer ned fremkommer det at verdens 62 rikeste personer har mer penger enn halvparten av verdens befolkning. Tallenes tale er at de totale ressursene i verden er veldig ulikt fordelt, og det går hardest utover en stadig større andel av verdens befolkning som ikke engang får dekket helt grunnleggende behov.
Problemet er ikke at noen få klarer å skape store verdier, men at disse verdiene ikke blir beskattet på en måte som gjør det mulig å omfordele noe til fellesskapet. Utfordringen står høyt på dagsorden, og Organisasjonen for økonomisk samarbeid og utvikling (OECD) er opptatt av å finne frem til løsninger som gir en bedre fordeling av rikdommen.
En løsning vil kreve internasjonale avtaler om skattelegging, noe som er vanskelig når mange land ønsker å være skatteparadiser for de store selskapene. Dette fordi det er lønnsomt både for selskapene og landene som har slike regler. Det er også nødvendig at store institusjoner våger å ta tak i problematikken. EU gjør det. Ikke bare skriver de ut store skatteregninger til de største aktørene som Apple, Amazon, Google og Facebook, men de bruker også domstolene til å forfølge land i Europa som har skatteregler som bryter med fellesskapets interesser.
Verdens utfordringer med å få en mer rettferdig fordeling av ressursene vil ikke løses med enkeltstående tiltak, men alt er bedre enn slik det er i dag. Det vil fortsatt være internasjonalt samarbeid og koordinert skattelovgivning som fører til løsninger. Internasjonal fagbevegelse, som Parat er en del av, spiller en rolle i å bidra til disse endringene.
Hans-Erik Skjæggerud Leder i Parat
Facebook: facebook.com/HansErikSkj/ Twitter: @Skjaeggerud



Skalljakke for vår og sommer. Vind- og vannavvisende i dame og herrestørrelse 555 kroner *

Hettegenser i økologisk bomull, leveres i dame og herrestørrelse 379 kroner *

T-shirt i økologisk bomull, leveres i dame og herrestørrelse 149 kroner *

Parat har valgt ut et lite utvalg kvalitetsklær. Medlemmer og tillitsvalgte kan bestille klærne i parat.shop.idegroup.no og betaler kun vår innkjøpspris.
Parat betyr at vi alltid står klar, uansett når du trenger hjelp. Et enkelt norsk ord som er tydelig i sitt budskap og som har fått Språkrådets pris for nettopp dette.
Fargen er oransje, som gir varme og som signaliserer glede, bevegelse og nytelse. Oransje virker oppløftende og den jager triste tanker på dør. Oransje stimulerer også til aktivitet, nysgjerrighet og kreativitet.

Garantert knallgod sparerente

En fastrentekonto passer for deg som har minst 25 000 kroner, og kan binde pengene i 6 eller 12 måneder. Du får en god og forutsigbar avkastning.
Priser: - Innskudd med binding i 6 måneder: 1, 8 0 % - Innskudd med binding i 12 måneder: 1, 80 %
Prisene på Fastrenteinnskudd er nominelle renter gjeldende per 15.9.2017 og kan endres på kort varsel. Sjekk gjensidigebank.no for dagens priser og bestill fastrenteinnskudd i nettbanken. Dersom du ikke allerede er kunde, åpner du enkelt konto ved å bruke BankID.